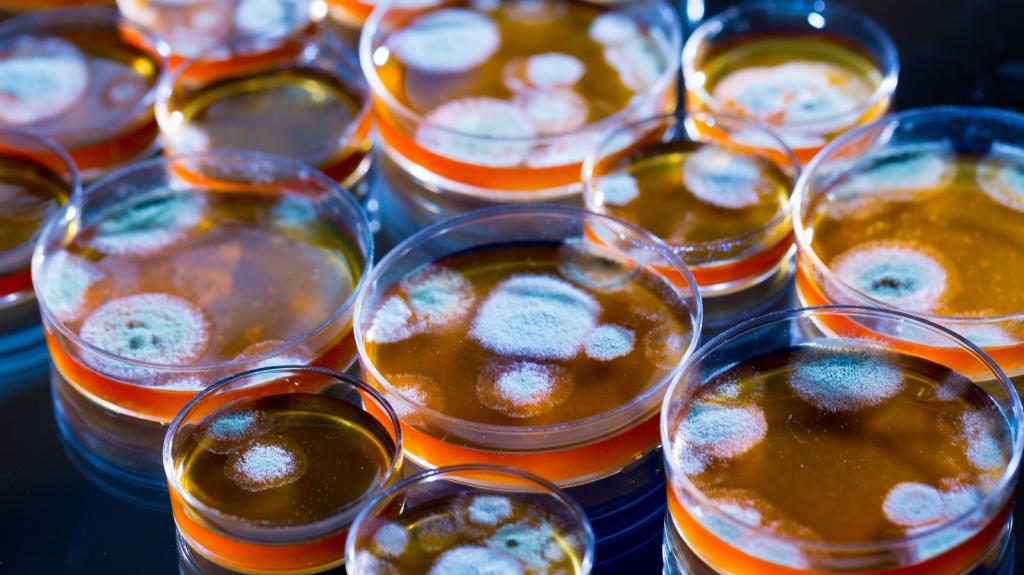
Антибиотик пинициллин

Сульфаниламиды — противомикробные средства, производные
амида сульфаниловой кислоты (белый стрептоцид). Их
открытие подтвердило предвидение П.Эрлиха о возможности селективного поражения
микроорганизмов цитотоксическими веществами резорбтивного действия. Первый
препарат этой группы пронтозил (красный стрептоцид) предупреждал гибель
мышей. зараженных десятикратной летальной дозой гемолитического
стрептококка.
На основе молекулы сульфаниламида во второй половине 30-х годов было
синтезировано много других соединений (норсульфазол, этазол, сульфазин, сульфацил
и др.). Появление
антибиотиков снизило интерес к сульфаниламидам, однако клинического значения они
не потеряли, в настоящее время широко используются
«долгодействующие» (сульфапиридазин, сульфален и др.) и особенно комбинированные препараты (ко-тримоксазол и
его аналоги, в состав которых помимо сульфаниламида входит триметоприм).
Препараты имеют широкий спектр противомикробного действия (грамположительные и
грамотрицательные бактерии, хламидии, некоторые простейшие — возбудители малярии
и токсоплазмоза, патогенные грибы — актиномицеты и др.).
Сульфаниламиды делятся на следующие группы:
1. Препараты, полностью всасывающиеся в желудочно- кишечном тракте и быстро
выводящиеся почками: сульфатиазол (норсульфазол), сульфаэтидол (этазол),
сульфадимидин (сульфадимезин), сульфакарбамид
(уросульфан ).
2. Препараты, полностью всасывающиеся в желудочно- кишечном
тракте, но медленно выводящиеся почками
(долгодействующие): сульфаметоксипиридазин (сульфапиридазин),
сульфамонометоксин, сульфадиметоксин, сульфален.
3. Препараты, плохо всасывающиеся из желудочно-кишечного тракта и действующие
в просвете кишечника: фталилсульфатиазол (фталазол),
сульфагуанидин (сульгин),
фталилсульфапиридазин (фтазин), а
также сульфаниламиды, конъюгированные с салициловой
кислотой — салазосульфапиридин, тесалазин (салазопиридазин), салазодиметоксин.
4. Препараты для местного применения: сульфаниламид (стрептоцид),
сульфацетамид (сульфацил-натрий), сульфадиазин серебра
(сульфаргин)- последний, растворяясь, высвобождает ионы серебра,
обеспечивающие антисептический и противовоспалительный эффект.
5. Комбинированные препараты: ко-тримоксазол (бактрим, бисептол), содержащий триметоприм с сульфаметоксазолом
или сульфамонометоксин с триметопримом
(сульфатон), являются также противомикробными средствами с широким спектром
действия.
Первая и вторая группы, хорошо всасывающиеся в желудочно- кишечном тракте,
применяются для лечения системных инфекций; третья — для лечения кишечных
заболеваний (препараты не всасываются и действуют в просвете пищеварительного
тракта); четвертая — местно, а пятая (комбинированные препараты с триметопримом)
эффективно действуют при инфекциях дыхательных и мочевыводящих путей,
желудочно-кишечных заболеваниях.
Механизм действия. Сульфаниламиды вызывают бактериостаз . Они являются
конкурентными антагонистами парааминобензойной кислоты (ПАБК), необходимой
микроорганизмам для синтеза фолиевой кислоты: последняя в коферментной форме
(дигидрофолиевой, тетрагидрофолиевой кислот) участвует в образовании
пуриновых и пиримидиновых оснований, обеспечивающих рост и развитие
микроорганизмов. Сульфаниламиды близки по химическому строению к ПАБК и поэтому
захватываются микробной клеткой вместо ПАБК. В результате останавливается синтез
фолиевой кислоты. Клетки человека не способны синтезировать фолиевую кислоту
(она поступает с пищей), чем и объясняется избирательность антимикробного
действия этих препаратов. Сульфаниламиды не влияют на бактерии, сами образующие
ПАБК. В присутствии гноя, крови, продуктов разрушения тканей, содержащих большое
количество ПАБК, препараты не эффективны. Лекарственные средства, которые в
результате биотрансформации образуют ПАБК (новокаин, дикаин), являются
антагонистами сульфаниламидов.
Комбинированные препараты: ко-тримоксазол (бактрим, бисептол), сульфатон, в
состав которых, кроме сульфаниламидных препаратов (сульфаметоксазол, сульфамонометоксин), входит триметоприм, являются высокоактивными
антибактериальными средствами. Триметоприм, ингибируя редуктазу дигидрофолиевой кислоты, блокирует ее
переход в активную тетрагидрофолиевую кислоту. Поэтому при введении
комбинированных сульфаниламидных препаратов тормозится не только синтез фолиевой
кислоты, но и ее превращение в активный кофермент (тетрагидрофолат). Препараты обладают бактерицидной активностью в
отношении грамположительных и грамотрицательных бактерий.
Основной путь введения сульфаниламидов — через рот. В тонком кишечнике они
быстро и полно всасываются (кроме утяжеленных препаратов — фталазол,
фтазин, салазосульфаниламиды, назначаемых при кишечной
инфекции), в крови связываются с белками плазмы, а затем, постепенно
освобождаясь из связи, начинают проявлять противомикробное действие,
антимикробной активностью обладает только свободная фракция. Почти все
сульфаниламиды хорошо проходят тканевые барьеры, в том числе гепатогематический,
гематоэнцефалический, плацентарный. В печени биотрансформируются, часть
выделяется в желчь (особенно долгодействующие, с успехом поэтому применяемые при
инфекциях желчевыводящих путей.
Основной путь биотрансформации сульфаниламидов — ацетилирование. Ацетилированные метаболиты теряют антибактериальную
активность, плохо растворимы, в кислой среде
мочи могут образовывать кристаллы, которые повреждают или закупоривают
почечные каналы. При инфекции мочевых путей назначают
сульфаниламиды, малоацетилирующиеся и выделяющиеся с мочой в
свободной форме (уросульфан, этазол).
Другой путь биотрансформации — глюкуронидация. Большинство
долгодействующих препаратов (сульфадиметоксин,
сульфален) теряют
активность, связываясь с глюкуроновой кислотой. Образующиеся
глюкурониды хорошо растворимы (отсутствует опасность кристаллурии).
Однако их назначение в раннем возрасте весьма опасно, так как функциональная
незрелость глюкуронилтрансферазы (катализатор глюкуронидации) приводит к
накоплению сульфаниламида в крови и интоксикации. Выделяются сульфаниламиды и
продукты их биотрансформацин главным образом с мочой. При заболевании почек
экскреция замедляется — могут возникнуть токсические эффекты.
Несмотря на выраженную избирательность действия, сульфаниламидные препараты
дают многочисленные осложнения: аллергические реакции, поражение паренхиматозных
органов (почек, печени), нервной системы, крови и кроветворных органов. Частое
осложнение — кристаллурия как результат кристаллизации сульфаниламидов и их
ацетилированных метаболитов в почках, мочеточниках, мочевом пузыре. Выпадая в
осадок, они образуют песок, камни, раздражающие почечную ткань, закупоривающие
мочевые пути и приводящие к почечным коликам. Для профилактики назначают
обильное питье, снижают кислотность мочи (для подщелачивания мочи назначают
цитраты или гидрокарбонат натрия). Очень эффективно использование комбинаций,
состоящих из 2-3 сульфаниламидов (вероятность кристаллурии снижается в 2-3
раза).
Осложнения со стороны крови проявляются цианозом,
метгемоглобинемией, гемолитической анемией, лейкопенией,
агранулоцитозом.
Цианоз развивается вследствие блокады карбоангидразы эритроцитов, это
затрудняет отдачу углекислоты и оксигенирование гемоглобина. Угнетение
активности пероксидаз и каталаз способствует накоплению в эритроцитах перекисей
и последующему окислению железа гемоглобина (метгемоглобин). Эритроциты,
содержащие сульфагемоглобин, теряют осмотическую стойкость и
лизируются (гемолитическая анемия).
В костном мозге под влиянием сульфаниламидов может наблюдаться повреждение
кровообразующих клеток, что приводит к развитию
агранулоцитоза, анемии апластического характера.
Образование клеточных элементов крови происходит при обязательном участии
фолиевой кислоты, которую организм получает с пищей, либо в качестве продукта
жизнедеятельности сапрофитной микробной флоры кишечника: сульфаниламиды при
длительном применении угнетают сапрофитные микроорганизмы кишечника, а если при
этом имеет место недостаточное поступление фолиевой кислоты с пищей, то может
возникнуть апластическая анемия.
Возникновение лейкопении объясняется блокадой цинксодержащих ферментов,
которые в большом количестве содержатся в лейкоцитах. Имеет значение и
непосредственное токсическое влияние сульфаниламидов на лейкоциты, как
производных анилина.
Действие сульфаниламидов на центральную нервную систему проявляется в виде
головокружений, головных болей, замедления реакций, депрессии. Возможны
поражения периферической нервной системы в виде невритов, полиневритов
(гиповитаминоз В1, нарушение ацетилирования
холина).
Сульфаниламиды, особенно бактрим, нельзя назначать беременным женщинам, так
как эти препараты обладают тератогенным действием, создают опасность для
внутриутробного развития плода. Кормящие женщины не должны принимать
сульфаниламиды, так как они выводятся с молоком.
Хотя значение сульфаниламидов для клинической практики в последнее время
снизилась из-за большого количества устойчивых штаммов, комбинированные
препараты по-прежнему широко применяются: высокая антибактериальная активность,
медленно развивается устойчивость, низкий процент осложнений.
Используются они при мочевых и кишечных инфекциях, заболеваниях дыхательных
путей (бронхиты, отиты, синуситы),
ко-тримоксазол
назначают больным СПИДом при пневмоцистной пневмонии, которая
является основной причиной смерти таких пациентов.
При местном применении надо помнить; что препараты действуют только в чистой
ране, так как присутствие гноя, некротических тканей, крови содержит большое
количество ПАБК, что тормозит антибактериальную активность сульфаниламидов.
Поэтому надо предварительно обработать рану, промыть перекисью водорода и
другими антисептиками, а затем наносить препарат. Кроме того, сульфаниламиды
тормозят образование грануляций, поэтому в период заживления раны их надо
заменить другими местными средствами.
Бронхитом называют заболевание, для которого характерно воспаление слизистой оболочки бронхов. Такое патологическое состояние протекает на фоне сильного кашля, затрудненного дыхания и повышенной температуры тела. Этой болезни подвержены абсолютно все возрастные группы людей.
Формы заболевания
Бронхит у взрослых и детей может быть хроническим, острым и обструктивным. В зависимости от формы патологии специалист принимает решение о необходимости использования тех или иных антибиотических препаратов.
- Острый бронхит обычно не требует применения антибактериальных лекарств. Исключение составляют лишь те редкие случаи, когда имеется высокий риск бактериальных осложнений. В этой ситуации лучшим антибиотиком при бронхите у взрослых людей является препарат, принадлежащий группе пенициллинов.
- Хронический тип заболевания в период обострения хорошо лечится при помощи аминопенициллинов, цефалоспоринов и макролидов. Также терапия подобными средствами показана пациентам пожилого возраста (для снижения риска осложнений и пневмонии).
- Обструктивный бронхит лечится только антибактериальными лекарствами, если у человека выявлена гнойная инфекция. О таком течении болезни может свидетельствовать высокая температура тела пациента. В этом случае лучшим антибиотиком при бронхите у взрослых людей послужит тот, который позволит избавиться от возбудителя заболевания. Назначать эффективное лекарство должен только специалист на основе данных анализа. Если болезнь носит тяжелый характер, то антибактериальные средства назначаются в уколах.
Когда следует использовать антибиотик при бронхите у взрослых (в таблетках, инъекциях и пр.)?
Согласно утверждениям врачей, воспаление слизистой бронхов не всегда лечится при помощи антибактериальных средств. Обычно в первые дни болезни специалисты воздерживаются от назначения подобных лекарств. Однако бывают и такие случаи, когда антибиотики просто необходимы. Например:
- если у пациента выявлена бактериальная инфекция, и его организм не справляется с ней на протяжении двух недель;
- если бронхит хронической формы носит затяжной характер, а также часто дает рецидивы, в результате чего сильно снижается иммунитет человека;
- если бронхит сопровождается слабостью, одышкой, проблемами с дыханием и высокой трудносбиваемой температурой (на протяжении нескольких суток);
- если у пациента имеются симптомы интоксикации, а в результатах анализов выявлено повышение СОЭ;
- при пожилом возрасте больного, а также высоком риске возникновения осложнений.
То, какой антибиотик лучше пить при бронхите взрослым людям, должен решать только врач после тщательного исследования и диагностики. Следует помнить, что самолечение такого заболевания чревато серьезными осложнениями и даже летальным исходом.
Действие антибактериальных препаратов
Прежде чем использовать антибиотик при бронхите у взрослых (в таблетках, уколах и пр.), следует выяснить, как они действуют при тех или иных формах заболевания.
В классической схеме терапии рассматриваемого заболевания обычно применяют препараты из группы пенициллинов. При этом однозначно ответить на вопрос о том, какой антибиотик лучше при бронхите у взрослого, невозможно. Все зависит от формы и характера текущей болезни, особенностей организма пациента, а также чувствительности бактерий.
Обычно при воспалении слизистой бронхов врачи назначают своим пациентам антибиотики из следующих групп:
- Аминопенициллины (например, «Аугментин», «Амоксиклав» или «Амоксициллин»). Такие лекарственные средства способны разрушающим образом воздействовать на клеточные мембраны бактерий. Главным плюсом подобных препаратов является то, что они не вызывают серьезных побочных явлений. Что касается минусов, то к ним относят частые аллергические реакции, которые возникают на фоне использования медикаментов.
- Фторхинолоны (например, «Офлоксацин» или «Левофлоксацин»). Эти названия антибиотиков при бронхите у взрослых знакомы многим пациентам. Такие лекарства воздействуют на обширный перечень возбудителей (разрушают их ДНК). Подобные препараты могут назначаться специалистами еще до результатов анализа на чувствительность бактерий к антибиотикам. Главным недостатком фторхинолонов является то, что при длительном использовании они способны вызывать дисбактериоз.
- Цефалоспорины (например, «Цефтриаксон», «Цефазолин», «Цефтазидим», «Супракс»). Такие названия антибиотиков при бронхите у взрослых людей должны насторожить, так как они могут вызывать сильнейшую аллергию. Именно поэтому их назначают с особо осторожностью. Основным достоинством подобных лекарств является то, что они способны замедлять выработку белка в бактериальных клетках, в результате чего останавливается процесс размножения возбудителя болезни и происходит его гибель.
- Макролиды (например, «Мидекамицин», «Сумамед» или «Азитромицин»). Это одни из лучших антибиотиков при бронхите у взрослых. Отзывы специалистов сообщают, что действующее вещество подобных препаратов способствует нарушению выработки белка в бактериальных клетках, что в конечном итоге приводит к остановке размножения патогенных микроорганизмов и их гибели. Обычно такие лекарства назначают при продолжительном течении заболевания или же в том случае, когда другие средства вызывают аллергическую реакцию.
Список лучших антибиотиков от бронхита у взрослых пациентов по приемлемой цене
Большинству пациентов, которые страдают от воспаления слизистой бронхов, интересно не только то, какие препараты эффективней всего справятся с их недугом, но и то, какие из них имеют доступную цену.
Специалисты утверждают, что лучшие антибиотики при бронхите у взрослых людей не всегда обладают завышенной стоимостью. Более того, многие из них имеют вполне приемлемые цены. К таким недорогим, но эффективным лекарствам относят:
- «Амоксициллин». Такой антибиотик из группы пенициллинов содержит в себе одноименное действующее вещество и активно назначается при воспалении легких и бронхитов, а также в процессе лечения ЛОР-органов, органов мочевыделительной системы, ЖКТ и прочих патологий. В продажу это лекарство поступает в таблетках, гранулах и капсулах. Как показывает медицинская практика, действие антибактериального медикамента начинается через полчаса после приема, а его эффект длится примерно 6 часов.
- «Бисептол». Из самых лучших антибиотиков при бронхите у взрослых людей этот самый недорогой. Он относится к группе сульфаниламидов и назначается только в комплексном лечении заболеваний дыхательной системы (например, при бронхите, абсцессе в легком и пневмонии). Такое средство имеет довольно много противопоказаний, а также вызывает большое количество побочных эффектов.
В медицине «Бисептол» используют очень давно. При этом следует отметить, что многие бактерии нечувствительны к действующему веществу упомянутого препарата, поэтому до начала терапии следует обязательно сдать анализ на чувствительность патогенных микроорганизмов.
- «Офлоксацин». Какой антибиотик в уколах лучше при бронхите у взрослого? Отвечая на этот вопрос, многие специалисты упоминают «Офлоксацин». Активное вещество такого средства из группы фторхинолов способно разрушать ДНК бактерий, что приводит к их гибели.
Рассматриваемый препарат назначается пациентам от множества бактерий, а также в случаях, когда иные антибиотические лекарства от бронхита не действуют.
Согласно инструкции, медикамент «Офлоксацин» активно применяют при воспалении слизистой бронхов. Также показаниями к применению этого лекарства является пневмония и заболевания других органов. Следует отметить, что подобное средство запрещается принимать беременным женщинам и кормящим матерям, несовершеннолетним людям, а также тем, у кого обнаружена высокая чувствительность к веществам медикамента.
Подбирать дозировку «Офлоксацина» должен только врач в индивидуальном порядке, так как имеется огромный риск развития побочных явлений со стороны сердечно-сосудистой, мочеполовой и нервной системы.
Другие антибиотические средства
О том, какой антибиотик лучше принимать при бронхите взрослым пациентам, мы рассказали выше. Однако это не единственные препараты, эффективно борющиеся с заболеваниями дыхательной системы. Есть и другие средства, которые обладают широким спектром действия, но стоят они дороже. Рассмотрим эти медикаменты далее.
«Флемоксин-Солютаб»
Активным действующим компонентом такого лекарства является амоксициллина тригидрат. Также в состав препарата входят следующие вспомогательные вещества: целлюлоза диспергируемая, ароматизатор лимонный, кросповидон, ароматизатор мандариновый, магния стеарат, ванилин, целлюлоза микрокристаллическая, сахарин.
Это медикамент из ряда пенициллинов. Обычно его назначают при осложненном хроническом или остром бронхите. В продажу такое лекарство поступает в форме традиционных, а также жевательных таблеток, которые обладают приятным вкусом.
Кроме взрослых людей, «Флемоксин-Солютаб» активно назначается и детям. Побочные явления после приема подобного препарата возникают крайне редко.
«Аугментин»
Это один из лучших антибиотиков при бронхите у взрослых людей. Его активным веществом является амоксициллин (в форме тригидрата), а также клавулановая кислота (в виде калиевой соли). Также в состав медикамента входят такие вспомогательные компоненты, как карбоксиметилкрахмал натрия, магния стеарат, коллоидный кремния диоксид и МКЦ.
«Аугментин» представляет собой средство из группы аминопенициллинов. Оно подавляющим образом воздействует на размножение бактерий, а также не позволяет им синтезировать в-лактамазу, которая защищает их от пенициллинов. Такое лекарство назначается при воспалительной инфекции, спровоцированной патогенными микроорганизмами.
«Аугментин» очень удобен в применении, так как выпускается в нескольких формах (в виде таблеток, инъекции, порошка для суспензии и капель). Побочные реакции после использования такого препарата возникают редко.
«Сумамед»
Действующим компонентом такого лекарства является азитромицина дигидрат. Также в состав антибиотика входят следующие вспомогательные вещества: крахмал прежелатинизированный, безводный кальция гидрофосфат, целлюлоза микрокристаллическая, гипромеллоза, магния стеарат, натрия лаурилсульфат и крахмал кукурузный.
Такой медикамент из ряда макролидов назначается пациентам от обширного перечня болезней инфекционно-воспалительного характера. Его можно приобрести в таблетках, капсулах и порошке с ароматом клубники.
«Сумамед» известен самым непродолжительным сроком применения. Для устранения всех признаков бронхита обычно достаточно принять три таблетки.
Рассматриваемый препарат довольно хорошо переносится пациентами. Он редко способствует развитию побочных реакций. Исключением являются лишь случаи неправильного приема или передозировки.
«Азитромицин»
Основным компонентом такого лекарства является азитромицин (в форме дигидрата). Также в его состав входят следующие дополнительные вещества: кроскармеллоза натрия, натрия лаурилсульфат, крахмал прежелатинизированный, магния стеарат, кальция гидрофосфат.
«Азитромицин» назначается пациентам от заболеваний, которые были вызваны различными бактериями (например, при бронхите и воспалении легких). Выпускается медикамент в капсулах и таблетках.
Через 3 дня лечения препарат полностью устраняет все признаки бронхита. Однако при его приеме следует учитывать следующие противопоказания: наличие повышенной чувствительности к компонентам лекарства, период беременности и кормление грудью. Что касается побочных реакций, то среди них часто возникающими являются: рвота, тошнота, диарея, аллергическая реакция.
«Цефазолин»
Что делать, если по тем или иным причинам пациенту нельзя принимать таблетки? Какой антибиотик лучше при бронхите у взрослого человека? «Цефазолин» — эффективное средство, которое поступает в продажу в виде ампул с порошком, предназначенным для приготовления инъекций. Это относительно старый медикамент из ряда цефалоспоринов. Он назначается пациентам от многих видов бактерий, которые вызывают инфекционно-воспалительные болезни, в том числе пневмонию, все формы бронхита и абсцесс легкого.
Активным веществом «Цефазолина» является одноименный компонент. Он имеет минимум противопоказаний и считается одним из малотоксичных в своей группе. Однако такое лекарство нельзя использовать беременным и кормящим женщинам. Также следует отметить, что на фоне его приема вероятны побочные реакции со стороны мочевыделительной системы и ЖКТ.
«Цефтазидим»
Названия лучших антибиотиков при бронхите у взрослых людей должны знать не только специалисты, но и пациенты. Это позволит подобрать наиболее подходящий и безопасный препарат, а также определиться с его формой.
«Цефтазидим» выпускается в виде порошка для приготовления внутривенного или внутримышечного раствора. Его действующим компонентом является цефтазидим (в форме пентагидрата), а вспомогательным – натрия карбонат.
Рассматриваемый препарат из новых цефалоспоринов, является антибиотиком третьего поколения. Он назначается при гнойно-септических состояниях тяжелого характера, а также осложненных инфекциях органов дыхания. «Цефтазидим» помогает справиться с острым и хроническим бронхитом и пневмонии. Он противопоказан к применению при индивидуальной непереносимости, а с осторожностью его назначают людям с кровотечениями и почечной недостаточностью.
Среди побочных явлений после использования лекарства возможны следующие: кровь из носа, аллергические реакции, изменение состава крови, заболевания органов пищеварительной системы, проблемы в работе НС.
Особенности применения антибактериальных лекарств
Теперь вам известно, какой антибиотик лучше пропить при бронхите у взрослого человека. Однако перед приемом того или иного препарата следует узнать, что антибиотический курс нельзя прерывать, а также сокращать или же увеличивать срок лечения, который был назначен врачом.
В процессе терапии бронхита антибактериальными препаратами, нужно знать следующее:
- Прием любых антибиотиков необходимо привязать ко времени, с учетом часового промежутка, рекомендованного в инструкции по применению. То есть, при лечении периоды между приемом лекарства должны быть равными, а если медикамент принимается единожды в сутки, то делать это следует в одно и то же время. Это позволит поддерживать в организме необходимую концентрацию активного компонента, и борьба с микробами будет вестись регулярно.
- На фоне приема антибиотиков необходимо контролировать состояние здоровья пациента, выявлять улучшения или, наоборот, ухудшения, а также побочные эффекты. Если через два дня улучшений нет, то препарат лучше заменить другим.
- Следует обязательно соблюдать все меры гигиены, наладить питьевой режим и скорректировать рацион питания. Это нужно, чтобы организм человека смог бороться с бактериями, а токсичные вещества постепенно удалялись.
- Вместе с антибактериальными средствами специалист должен назначить пациенту противогрибковые и антигистаминные лекарства.